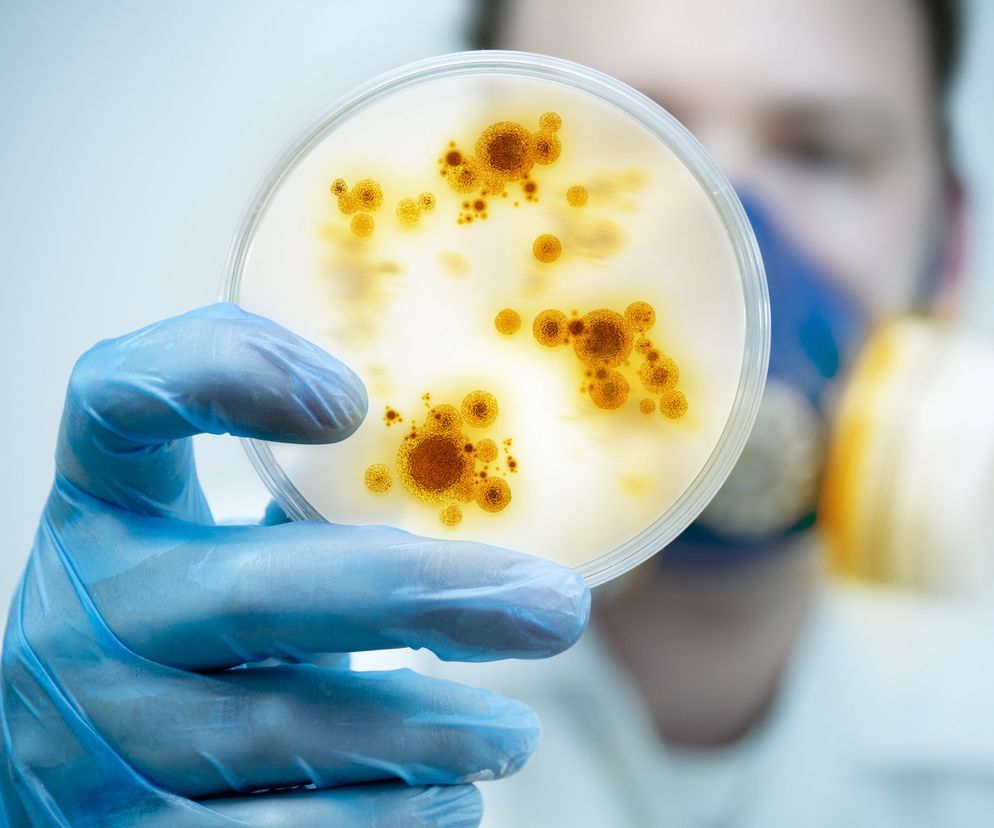

Spis treści
Klebsiella-pneumoniae, czyli pałeczka zapalenia płuc, to bakteria, która w naturalnych warunkach bytuje głównie w przewodzie pokarmowym, a także w jamie nosowo-gardłowej oraz na skórze. Zakażenia wywołane pałeczką zapalenia płuc dzielimy na zakażenia szpitalne i pozaszpitalne.
Do zakażeń pozaszpitalnych dochodzi najczęściej u osób z osłabionym układem odpornościowym, obciążonych chorobami przewlekłymi, takimi jak cukrzyca, alkoholizm, przewlekła obturacyjna choroba płuc oraz ludzi starszych.
W związku z tym, że z łatwością rozmnaża się na oddziałach i nabywa oporność na szereg antybiotyków, może się przyczynić także do zakażeń szpitalnych. Pałeczkę zapalenia płuc wykrywa się około 20 proc. pacjentów w szpitalu, którzy nie otrzymują antybiotyków. Zakażenia te najczęściej dotyczą pacjentów na oddziałach kardiochirurgii.
Klebsiella-pneumoniae (pałeczka zapalenia płuc) - jakie choroby powoduje?
Pałeczka zapalenia płuc, jak sugeruje nazwa, najczęściej odpowiada za zapalenie tego narządu oddechowego, szczególnie u chorych, u których stosuje się wspomaganie oddychania. W niektórych przypadkach jest przyczyną powstawania miejsc martwiczych w płucach (kieszonki ropne), a nawet ropnia płuc. Klebsiella-pneumoniae może także wywołać mniej poważne choroby dróg oddechowych, jak zapalenie oskrzeli, które jest zazwyczaj infekcją nabytą w szpitalu.
Pałeczka zapalenia płuc może się przyczynić także do zakażeń pozapłucnych, np. zakażenia miejsca operowanego, układu pokarmowego, nerwowego u niemowląt (zapalenie opon mózgowo-rdzeniowych), zakażenia dróg moczowych u dzieci i dorosłych (zwłaszcza u chorych z drenażem dróg moczowych), dróg żółciowych oraz stany zapalne zatok czy ucha środkowego. Może także odpowiadać za stany zapalne tkanek miękkich oraz zapalenie szpiku, a nawet wstrząs endotoksyczny lub posocznicę.
Klebsiella-pneumoniae jest szczególnie groźna dla noworodków, szczególnie wcześniaków. Śmiertelność wśród wcześniaków z najniższą masą urodzeniową wynosi nawet 30 proc.
Klebsiella-pneumoniae (pałeczka zapalenia płuc) - jak można się zarazić?
- drogą kropelkową - gdy osoba chora mówi, kaszle lub kicha i jednocześnie wydala kropelki śliny zawierające bakterię, która przedostaje się na inne osoby;
- drogą pokarmową, np. przez spożycie zakażonego pokarmu, zjedzenie posiłku brudnymi rękami itp.;
Warto wiedzieć, że bakteria ta może przetrwać na powierzchniach, zwłaszcza tych wilgotnych i wodnych, np. w zlewach, na pozostałościach w naczyniach, wilgotnych ścierkach, na mydle, wokół zlewów, różnych pojemnikach, nawilżaczach, a nawet drenach.
Klebsiella-pneumoniae (pałeczka zapalenia płuc) - objawy
Zakażenie pałeczką zapalenia płuc daje objawy grypopodobne, takie jak wysoka gorączka i dreszcze. Dodatkowo pojawia się kaszel, któremu towarzyszy produkcja dużych ilości śluzu. Wykrztuszana wydzielina często jest gęsta i zabarwiona krwią.
Klebsiella-pneumoniae (pałeczka zapalenia płuc) - leczenie
W leczeniu infekcji wywołanych pałeczką zapalenia płuc stosuje się kolistynę. Warto wiedzieć, że Klebsiella pneumoniae jest oporna na działanie większości antybiotyków. Z tego powodu nazywa się ją też koszmarną bakterią. W styczniu 2017 roku w USA klebsiella stała się przyczyną śmierci kobiety z Reno w stanie Nevada. Zakażenia wywołanego przez bakterię nie dało się wyleczyć żadnym dostępnym na rynku antybiotykiem. Pacjentka dostała ich w sumie aż 26. Niektóre szczepy tej bakterii są w stanie wytworzyć tzw. karbapenemazy KPC, czyli enzymy rozkładające wszystkie dostępne dzisiaj tzw. antybiotyki betalaktamowe.